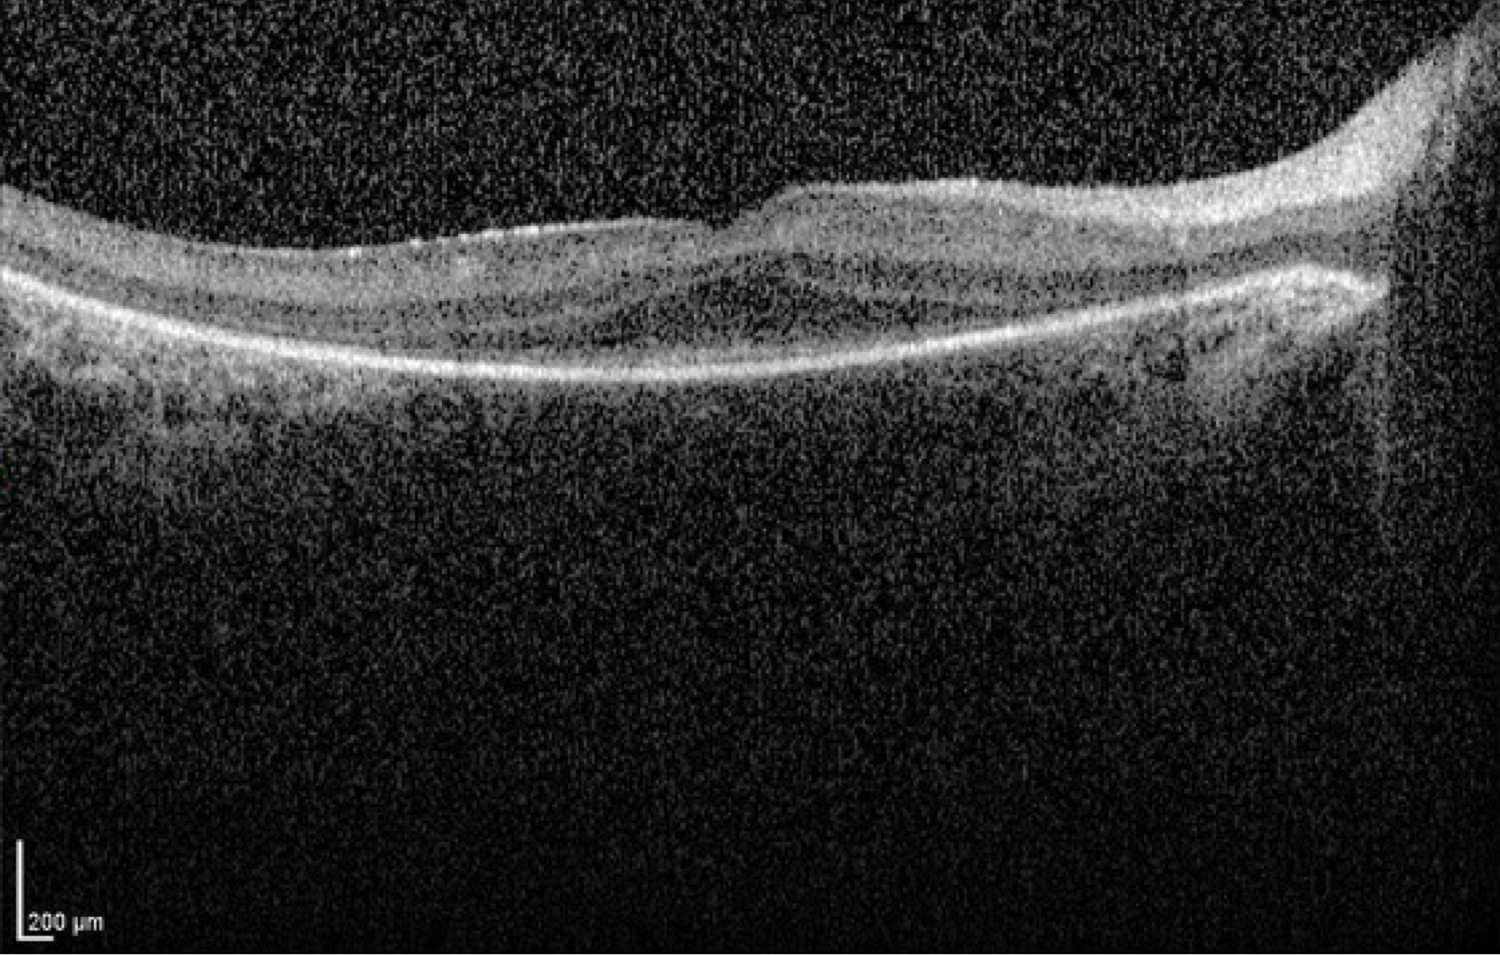

Big 14 Self-Assessment
Case 9
Case 9 is a six year old girl who was visually inattentive and had pronounced nystagmus at 4 months of age. An electroretinogram was performed at that time and no responses could be detected under any stimulus conditions. Her parents have normal vision. On our examination, her visual acuity was 20/80. Streak retinoscopy revealed about 5 diopters of hyperopia.